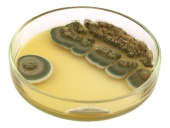

Recenzovaný Článek se zabývá vlivem relativní vlhkosti prostředí na pravděpodobnost výskytu plísní na hliněných omítkách již vyzrálých, nebo těsně po aplikaci. Byly vybrány čtyři typy omítek s různým obsahem organických přísad a odlišnou hrubostí. U všech vzorků byl v průběhu jednoho měsíce zaznamenáván rozsah výskytu mikrobiálního napadení. Dále byl zkoumán vliv vlhkosti vzduchu během aplikace omítek, byly identifikovány druhy plísní a bakterií, které se na omítkách přirozeně vyskytují a identifikace byla provedena na živné půdě.